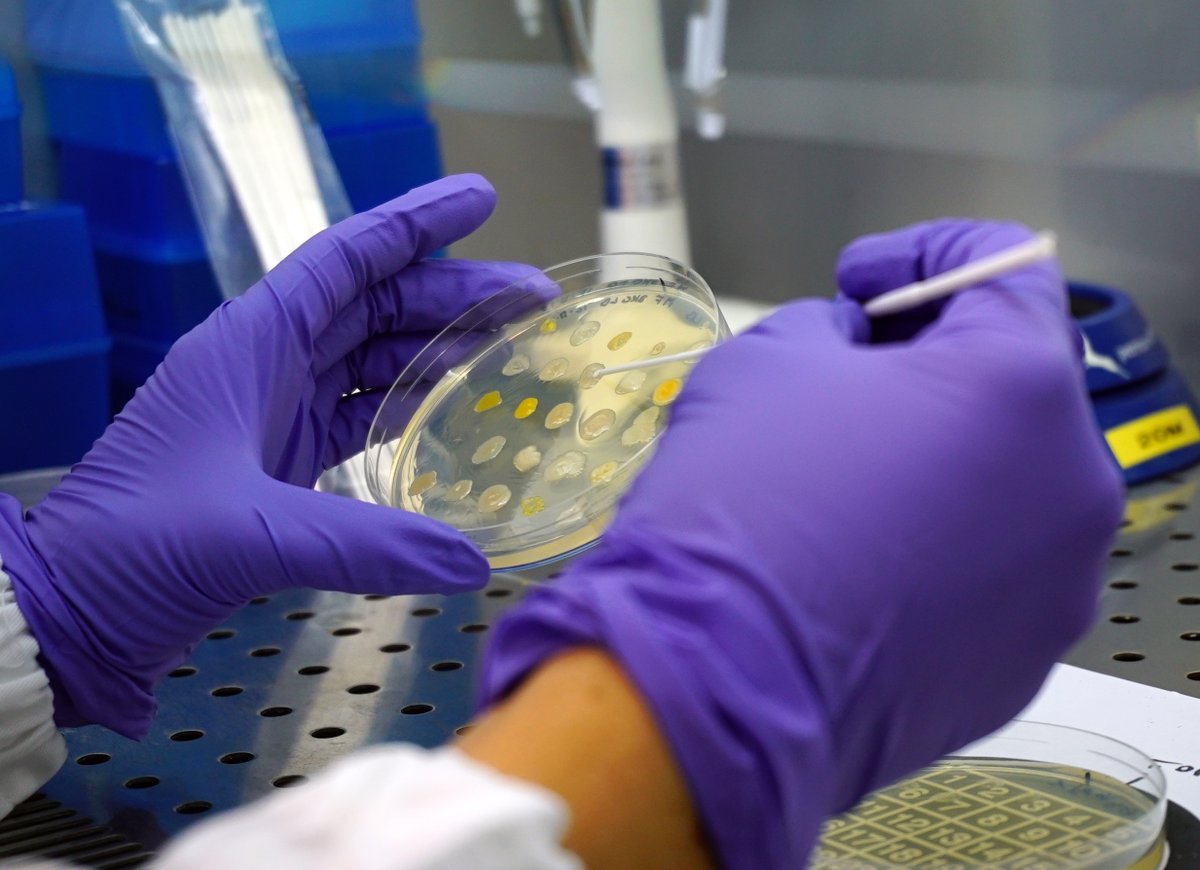
EU HERA (@ec_hera) on Twitter photo Tuberculosis is still global health threat. We're strengthening our response by speeding up development of & access to medicines through #EU4Health with @HaDEA_EU & <a href="/EMA_News/">EU Medicines Agency</a>: 
📌Funding MTBVAC vaccine development
📌 €5M for child-friendly TB medicines.
lnkd.in/gY_FkFSb Tuberculosis is still global health threat. We're strengthening our response by speeding up development of & access to medicines through #EU4Health with @HaDEA_EU & <a href="/EMA_News/">EU Medicines Agency</a>: 
📌Funding MTBVAC vaccine development
📌 €5M for child-friendly TB medicines.
lnkd.in/gY_FkFSb

Jessica El Rayes
@jessicaelrayes1
PhD
De Duve Institute- Collet lab💪
Marie Sklodowska-Curie Alumni
Scientist ❤️
ID: 1342973747796520960
26-12-2020 23:21:25
92 Tweet
80 Followers
248 Following





Looking forward to celebrate the International Microorganism Day at @RBINSmuseum with the Young Belgian Society for Microbiology (YBSM) 🤩

Games, stickers, fun books to read, and much more! Our printing materials are ready for #IMD23. Get ready to celebrate with us on the 16th of September! 🦠📚 Enjoy a 30% discount on the purchases of "Invisible Friends" 🦠Invisible Friends🦠 courtesy of the amazing Jake Robinson


✨The BCCM collections of #microorganisms BCCM Collections celebrate their 40th anniversary next week 🥳Come and have a look next 16/09 @RBINSmuseum in Brussels during #InternationalMicroorganismDay by Young Belgian Society for Microbiology (YBSM) and International Microorganism Day 🧫🦠Belspo


A round of applause! Students and colleagues at Lund University came together to recognise newly named physics laureate Anne L’Huillier. Drop a 👏 in the comments to congratulate our new Nobel Prize laureate. Video credit: Nina Ransmyr, Lund University









Tuberculosis is still global health threat. We're strengthening our response by speeding up development of & access to medicines through #EU4Health with @HaDEA_EU & EU Medicines Agency: 📌Funding MTBVAC vaccine development 📌 €5M for child-friendly TB medicines. lnkd.in/gY_FkFSb

📢 Come and work with us in the Biozentrum, University of Basel!

